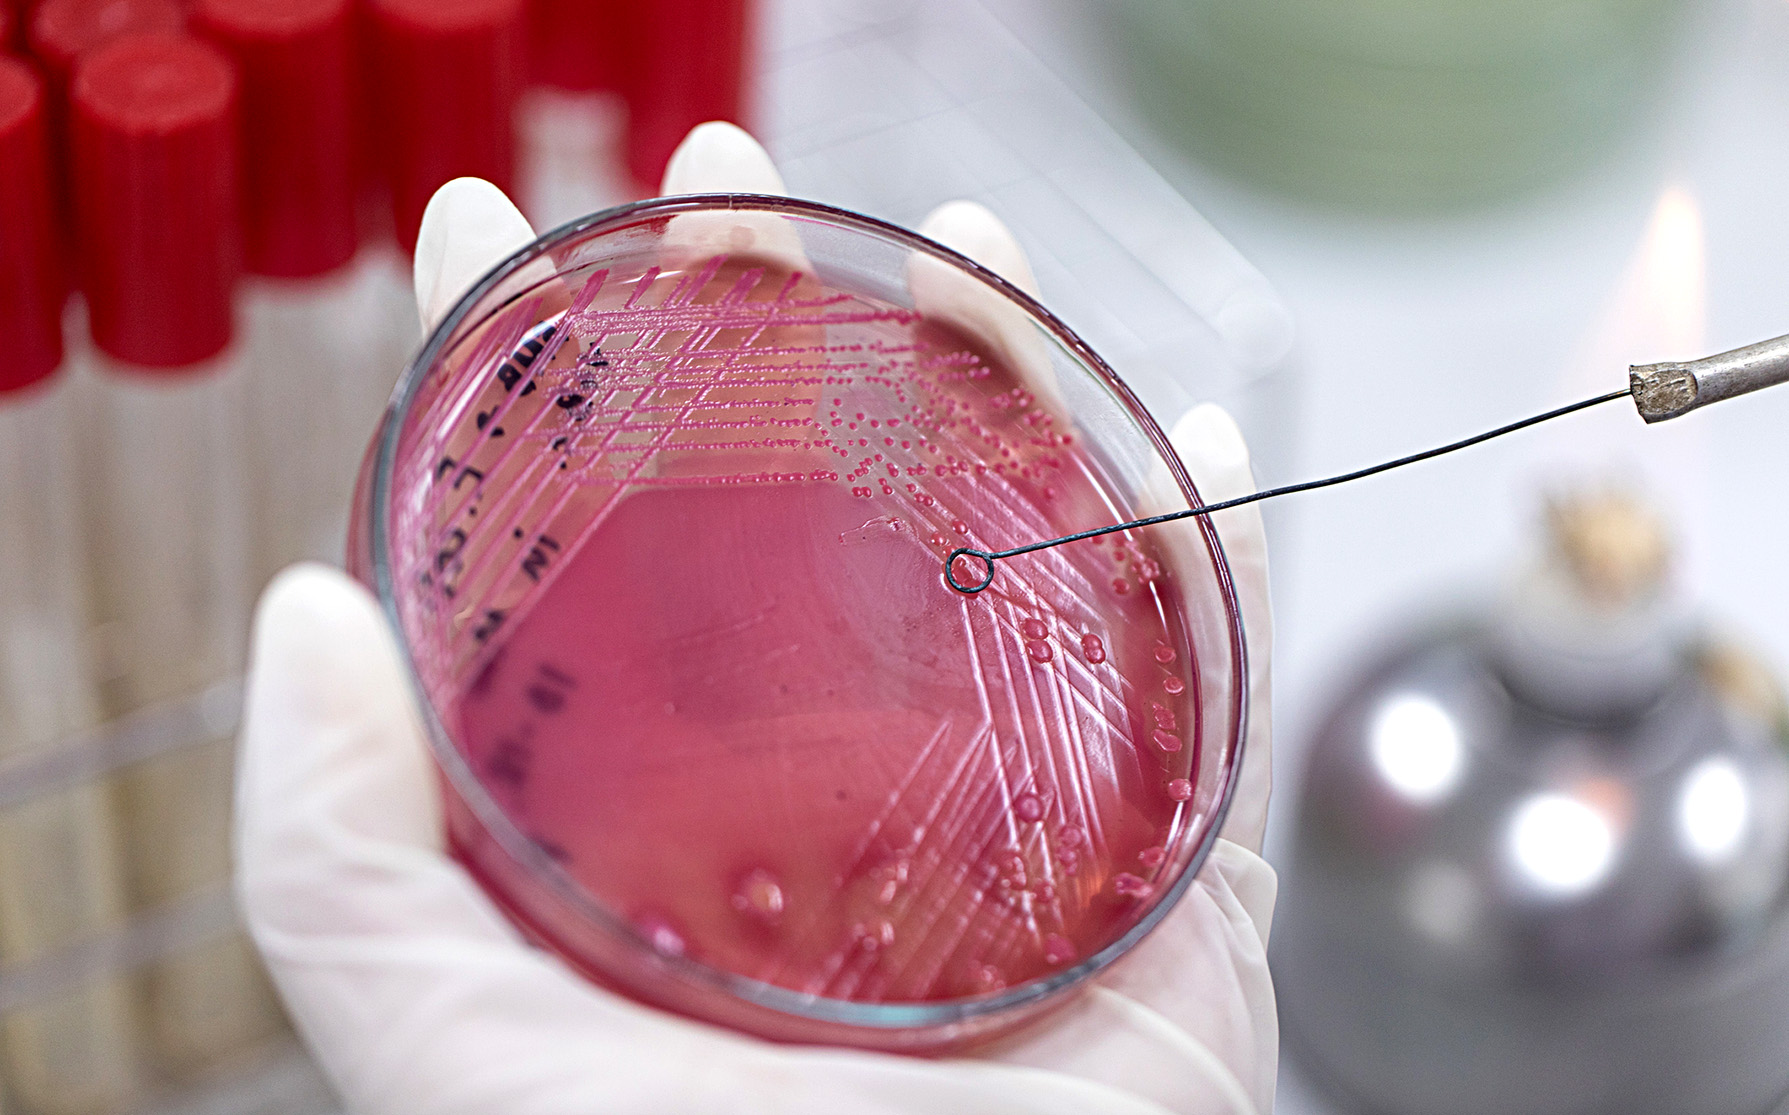
Tackling antimicrobial resistance and the looming threat of mirror life require global action

Every year, more than one million people die from antimicrobial resistance. It is one of the most important global health threats, according to the World Health Organization. This sentiment was echoed at the recent Jeddah Conference, where representatives from more than 57 countries pledged to move towards decisive multilateral action on antimicrobial resistance.
Antimicrobial resistance is also fundamentally a matter of health equity. It disproportionately affects low- and middle-income countries: diseases caused by bacteria that are resistant to antibiotics spread more quickly, and are more lethal, in developing countries. At the same time, high-income countries disproportionately contribute to the overconsumption and overproduction of antimicrobial drugs that can cause and exacerbate antimicrobial resistance in the first place.
This pattern of global inequity extends beyond antimicrobial resistance, with the Global South (countries of the developing world) often suffering the consequences of problems predominantly created by the Global North.
A new threat now looms. In a recent publication in Science, we joined an esteemed list of researchers in raising the alarm about risks of ongoing efforts to create “mirror life”. If created, mirror life could lead to the destruction of life, the environment and food systems across the globe, including exacerbating inequities that already exist in low- and middle-income countries. We must ensure that scientists and policymakers from developing countries are included as part of the discussions and leadership about governing mirror life.
Mirror life refers to organisms created with “mirror molecules”. Mirror molecules have the same structure as natural molecules, except they are flipped, like how one’s left hand is a mirrored version of one’s right hand. Proteins are made up of amino acids that are normally found in a “left-handed” form, and DNA is made up of nucleic acids that are normally found in a “right-handed” form. Mirror forms of these molecules, such as right-handed amino acids and left-handed nucleic acids, are rarely used in nature, but can be artificially created in laboratory settings. By putting together mirror proteins, DNA, and other mirror molecules, scientists may be able to create entire mirror lifeforms.
Spread unchecked
We argue in our paper that mirror bacteria (the form of mirror life most likely to be created first) could evade human, plant, and animal immune systems, which have evolved to protect against microbes found in nature. Beyond getting past our immune systems, mirror bacteria also could evade natural predators like viruses that target bacteria (bacteriophages), which would enable mirror bacteria to spread relatively unchecked throughout nature, with potentially devastating effects on the environment and the world’s food systems. A pandemic caused by mirror bacteria would have catastrophic effects worldwide. For these reasons, in our paper, we argue that mirror life should not be created. We call, as well, for broader governance around mirror molecules.
Mirror life may create unprecedented, worldwide risks, and its effects would be felt by all countries. The severity and scope of its impact could be quite unlike anything that has been seen before. Luckily, few laboratories are actively interested in the development of mirror life — and none of them are in developing countries. However, it would be a grave injustice if the discussion of governance around mirror life included only stakeholders in high-income countries, as it is the low- and middle-income countries that could be the most affected if mirror life were ever to be created. Hard as it is to imagine, the proliferation of mirror life, and its devastating consequences on human and animal immune systems, might require isolating bunkers to house humans and their life support systems — an expensive enterprise.
Covid-19 has demonstrated that the effects of novel biological threats hit hardest in the Global South. These countries are less able to provide emergency healthcare to those affected, and if we were to succeed in developing new drugs to counter mirror life, they would probably be amassed and stockpiled by high-income nations. This is the same pattern we’ve seen in practically every pandemic. The 1918 Influenza — which killed up to 50 million people — began spreading in Europe, yet South Africa and India were two of the worst affected countries. A pandemic due to mirror life could be much more disastrous.
It is imperative that those driving the threat from mirror bacteria recognise their responsibilities and actively engage leaders from low- and middle-income countries in the discussions around governance. Ensuring representation of the Global South will enable transparency and accountability. Engaging appropriate global entities to provide oversight and accountability over research into mirror life would be essential to facilitate the protection of all countries.
Countries and organisations in the Global North should work with regulators in developing countries to create governance for any laboratory that develops an interest in working on mirror life in the future. This would also prevent laboratories from dodging regulations by moving their research to developing countries.
Fortunately, scientists who are engaged in the research that would serve as a precursor to the creation of mirror life are cognisant of the risks. The development of mirror life is something that can still be halted. While an entire mirror bacterium could pose a significant threat, the synthesis of specific mirror biomolecules on their own do not pose similar risks — and, in fact, could lead to new medicines.
Oversight
For instance, mirror proteins have been touted as an option for creating drugs to fight HIV, still an ongoing pandemic disproportionately affecting regions such as southern Africa. Innovation in this space needs to be diffused worldwide, so that low- and middle-income countries can benefit just as much as high-income nations. The peaceful and beneficial uses of such precursor research underscore the need to engage experts everywhere in discussions about oversight and to instill a hyper-awareness as to when to stop the research before it becomes dangerous.
With mirror life, the world has the invaluable opportunity to avoid repeating the mistakes of the past. Practices that have led to antimicrobial resistance are key examples where actions taken by high-income countries can have negative effects in low- and middle-income countries. Similarly, (industrial) practices that have led to climate change have been largely led by countries of the Global North, with disproportionate impacts on the Global South. Air pollution has largely been caused by industrial corporations and high-income nations burning fossil fuels, yet it disproportionately affects low-income communities and causes diseases like lung cancer to become more prevalent in vulnerable populations.
Global action wasn’t taken rapidly enough to prevent the devastating consequences of antimicrobial resistance, climate change, and air pollution. The risks posed by the potential to create mirror life are unparalleled and fall in a class of their own. However, when it comes to mirror life, we have the chance to act wisely — now — and prevent a damaging worldwide impact. Incorporating global perspectives into the governance of mirror life is the only way to ensure we are all safe. DM
Wilmot G. James is a Professor in the Department of Health Services, Policy and Practice and Senior Advisor to the Pandemic Center in the School of Public Health, Brown University, Providence, Rhode Island. Vaughn S. Cooper is Professor in the Department of Microbiology and Molecular Genetics and a founder of the Center for Evolutionary Biology and Medicine, University of Pittsburgh School of Medicine, Pittsburgh, Pennsylvania.

Microbacteria in a laboratory. (Photo: iStock)
Microbacteria in a laboratory. (Photo: iStock)